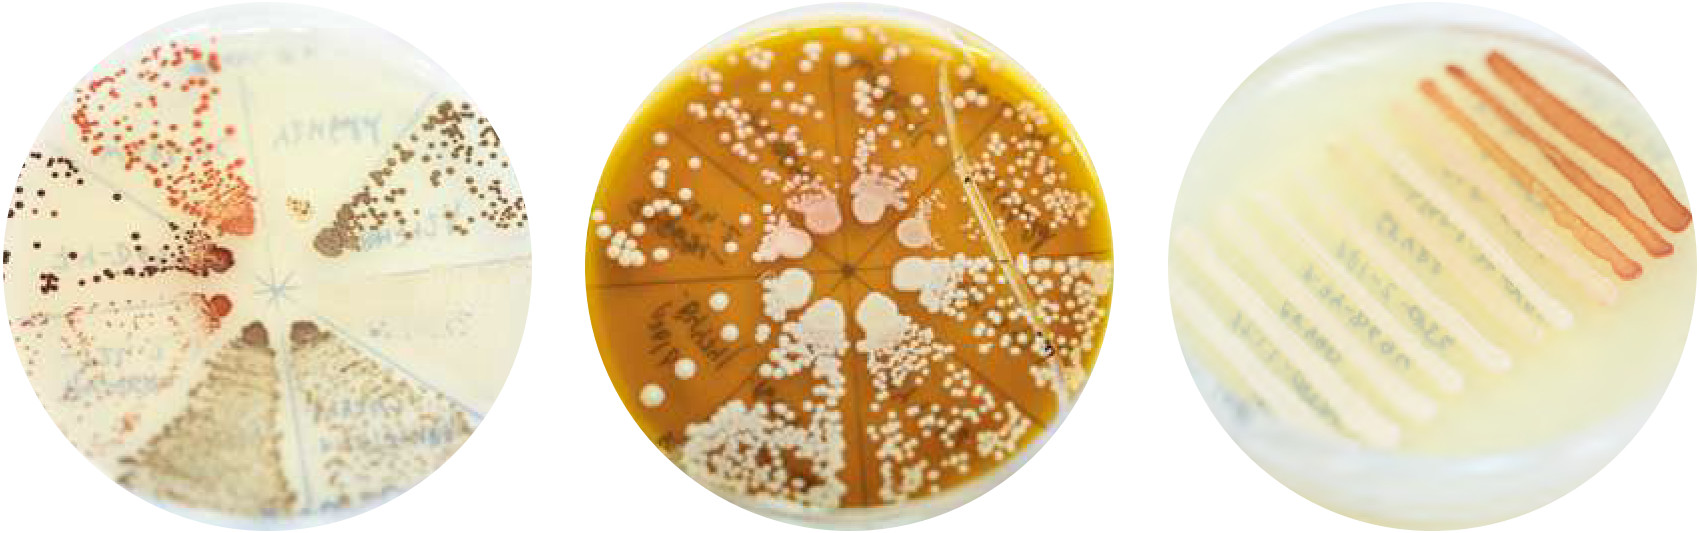

Санкт-Петербургский университетНаука
Кладовая генов
В Санкт‑Петербургском университете хранится более трех миллионов музейных экспонатов, собранных учеными за прошедшие 300 лет. Часть этой коллекции — генетические образцы растений, животных и микроорганизмов.
Развитие генетики в России во многом связано с работой универсанта-биолога Юрия Александровича Филипченко. В 1913 году ученый начал читать в Императорском Санкт-Петербургском университете первый в Российской империи курс лекций о законах наследственности и изменчивости организмов, а в 1919 году организовал единственную на тот момент в стране кафедру генетики.
Тогда же в Университете стала формироваться генетическая коллекция. Опираясь на законы генетики, ученые скрещивали разные формы растений и животных, отбирали штаммы микроорганизмов, а лучшие образцы сохраняли для дальнейшего изучения и демонстрации студентам.
Развитие генетической коллекции продолжилось в конце 1950-х годов. Тогда кафедру генетики Университета возглавил профессор Михаил Ефимович Лобашёв. Он проводил для обучающихся лекции о классических генетических законах и организовал масштабные работы по изучению причин и механизмов возникновения мутаций. Образцы, полученные в результате исследований того периода, заложили основу современной генетической коллекции СПбГУ.

Наглядная генетика
В последующие 70 лет научное собрание постоянно расширялось. Генетики Университета отбирали для коллекции такие формы растений, животных и микроорганизмов, на которых можно было проследить течение фундаментальных биологических процессов. В том числе обмен веществ, фотосинтез, формирование клеток и многое другое.
В фонд попадали образцы с мутациями в генах. «Это линии и штаммы организмов, полученные генетиками Университета при изучении наследственных признаков, — объясняет Антон Александрович Нижников, профессор, исполняющий обязанности заведующего кафедрой генетики и биотехнологии СПбГУ. — В ходе подобных исследований ученые могут определить ген, который отвечает за проявление интересующего их признака, например за синтез определенного химического соединения, а затем создать линию или штамм, у которых этот ген имеет измененную структуру (например, заблокирован или работает активнее)».

По получившимся образцам ученые понимают механизм действия гена и связанных с ним мутаций. Эти данные необходимы для расширения фундаментальных знаний о природе генов, а также для разработки инновационных способов лечения, новых медицинских препаратов и усовершенствования подходов к ведению сельского хозяйства.
«Стоит отметить, что все объекты в генетической коллекции Университета живые и генетически охарактеризованы, то есть ученым известна последовательность конкретных генов или всего генома организмов. Это ее важные отличия от других естественнонаучных коллекций СПбГУ», — говорит Антон Нижников.
Как отмечает профессор, ученые на протяжении многих десятилетий сохраняют в коллекции линии с уникальными геномами. Семена растений генетики высаживают раз в несколько лет, чтобы получить новые поколения, а микроорганизмам и животным создают комфортные условия для размножения.
Среди растений-мутантов
Сегодня в генетическом собрании СПбГУ насчитывается более 2300 образцов, распределенных по семи разделам. В первом из них, основанном профессором Университета Василием Сергеевичем Федо- ровым, представлена рожь и ее гибриды. Например, тритикале — зерновая культура, созданная путем скрещивания с пшеницей. Также в этом разделе имеются образцы ржи с ценными признаками. К примеру, рожь с коротким стеблем. Ее преимущество в том, что она устойчива к полеганию — наклону, из-за которого замедляется рост, снижаются объемы урожая и осложняется последующая его уборка с поля.
Законы Менделя — основные закономерности передачи наследственных признаков от родителей к потомкам. Сформулированы биологом Грегором Иоганном Менделем (1822–1884) в результате многолетних опытов по скрещиванию различных форм гороха посевного. Труды ученого положили начало современной генетике. Источник: bigenc.ru
«В коллекции ржи СПбГУ представлены и линии с разной окраской зерен, — добавляет Антон Нижников. — Отличие вызвано разным содержанием в образцах особых химических соединений — антоцианов. Эти вещества сегодня признаны полезными антиоксидантами, и потому генетики активно их изучают. Такая работа в том числе ведется в СПбГУ. Семена ржи с разной окраской позволяют нам исследовать процессы биосинтеза антоцианов в живых организмах».
Амилоиды у растений были впервые обнаружены учеными СПбГУ в сотрудничестве с коллегами из других научных организаций.
Второй раздел генетической коллекции, начало которому положили работы исследовательницы Университета Станиславы Иосифовны Нарбут, — линии редиса. Они помогают ученым СПбГУ узнавать больше о механизмах развития у растений запасающих корней — таких, которые накапливают питательные вещества. Также образцы демонстрируют разные изменения развития, в том числе карликовость, волнистость побегов и чрезмерно длинный стебель.
«Одно из центральных мест в этом разделе занимают линии редиса со спонтанными корневыми опухолями. Сегодня их активно изучает группа профессора Людмилы Алексеевны Лутовой, — приводит пример Антон Нижников. — Такие образцы важны для исследования генов и механизмов, отвечающих за дифференцировку клеток, процесс, в результате которого клетки приобретают специализацию и из стволовых превращаются в клетки конкретных тканей с конкретными функциями».
Различные мутации можно увидеть и на образцах садового гороха из третьего раздела генетической коллекции СПбГУ. В Университете хранятся линии с аномальным строением листьев и нетипичной формой семян. Имеются образцы, предназначенные для изучения амилоидов — крупных упорядоченных белковых комплексов, которые выполняют в клетках жизненно важные функции, а иногда могут провоцировать развитие неизлечимых заболеваний.
«В собрании также есть формы гороха с полезными для ведения сельского хозяйства свойствами. Например, способные вступать в удачный симбиоз с клубеньковыми бактериями — ризобиями. Благодаря такому взаимодействию можно снизить количество минеральных удобрений при выращивании гороха и при этом получить хороший урожай. Основы молекулярных механизмов таких благоприятных взаимодействий растений с микроорганизмами сегодня активно изучает коллектив исследователей центра мирового уровня „Агротехнологии будущего“ под руководством Игоря Анатольевича Тихоновича, профессора СПбГУ, декана биологического факультета, академика РАН», — добавляет Антон Нижников.
О том, чем полезны и опасны амилоиды и как ученые СПбГУ исследуют их с помощью образцов гороха посевного из генетической коллекции Университета, читайте в статье «Противоречивая природа амилоидов» Антона Александровича Нижникова, профессора, исполняющего обязанности заведующего кафедрой генетики и биотехнологии СПбГУ. Материал опубликован в журнале «Санкт-Петербургский университет» № 05 за 2022 год.

От дрожжей до мух
По словам ученого, микроорганизмы в генетическом собрании Университета тоже представлены тремя разделами. Один из них — единственная в России коллекция штаммов зеленых водорослей Chlamydomonas reinhardtii, основателями которой были исследователи Университета Константин Васильевич Квитко и Анна Владимировна Столбова. Этот раздел создали в СПбГУ для наблюдения за дыханием, питанием, движением и другими процессами в живых организмах. Помимо модельных объектов с нормальным развитием, в коллекции хранятся образцы с нарушениями разных функций. Например, «разучившиеся» получать энергию из света или имеющие пигментные мутации из-за изменения содержания зеленого пигмента — хлорофилла.
«Изучение Chlamydomonas reinhardtii имеет большое практическое значение. Во-первых, эти одноклеточные водоросли сегодня часто используют как высокобелковые кормовые добавки для сельскохозяйственных животных. Во-вторых, на основе этих микроорганизмов можно разрабатывать тест-системы для оценки экологической безопасности», — объясняет ценность коллекции водорослей Антон Нижников.
В СПбГУ изучением прионов занимается научная школа, которую возглавляет Сергей Георгиевич Инге-Вечтомов, почетный профессор СПбГУ, заведующий кафедрой генетики Университета с 1972 по 2015 год, академик РАН.
Исследователь отмечает, что в собрании Университета также есть штаммы хлебопекарных дрожжей Saccharomyces cerevisiae, несущие мутации в определенных генах или особые инфекционные белки — прионы. Подобные белки вызывают неизлечимые нейродегенеративные заболевания вроде бешенства у коров и болезни Крейтцфельдта — Якоба у человека. Также они выявлены у дрожжей, которые являются удобной моделью для изучения прионов.
Третья группа микроорганизмов в коллекции — дрожжи Komagataella phaffii, которые сегодня используются в фармацевтической отрасли для производства белка. Одним из первых с этим объектом стал работать генетик Университета Михаил Николаевич Смирнов. Сегодня в собрании СПбГУ хранится 45 штаммов, созданных Михаилом Смирновым и его последователями и способных синтезировать различные полезные соединения белковой природы, например ферменты и иммуномодуляторы.

Животные в собрании представлены линиями плодовых мух-дрозофил. Формирование этого раздела коллекции происходило с конца 1950-х. «Дрозофила — это классический объект для обучения студентов. С помощью линий дрозофил студенты получают уникальные практические навыки в решении генетических задач в рамках ряда курсов, таких как „Общая генетика“, „Генетический анализ“ и „Генетическая токсикология“, — рассказывает профессор Антон Нижников. — Также на дрозофилах изучают белки, которые принимают участие в процессах формирования эмбрионов и образования нервных клеток». При этом многие линии дрозофил, выведенные генетиками СПбГУ для исследований, не встречаются больше нигде в мире.
В настоящее время ученые Университета продолжают пополнять генетическую коллекцию, а образцы из собрания задействованы во многих научных проектах, в том числе международных, а также в образовательном процессе студентов бакалавриата, магистратуры и аспирантуры.

Подробнее о генетической коллекции СПбГУ читайте в статье Genetic Collections of St. Petersburg University, опубликованной в журнале Biological Communications. DOI: doi.org/10.21638/spbu03.2023.308
О том, чем полезны и опасны амилоиды и как ученые СПбГУ исследуют их с помощью образцов гороха посевного из генетической коллекции Университета, читайте в статье «Противоречивая природа амилоидов» Антона Александровича Нижникова, профессора, исполняющего обязанности заведующего кафедрой генетики и биотехнологии СПбГУ. Материал опубликован в журнале «Санкт-Петербургский университет» № 05 за 2022 год.
Антон Александрович Нижников, профессор, исполняющий обязанности заведующего кафедрой генетики и биотехнологии СПбГУ, профессор РАН, лауреат премии Президента РФ в области науки и инноваций для молодых ученых (2020 год)
Фото: все Алексей Лощилов
Хочешь стать одним из более 100 000 пользователей, кто регулярно использует kiozk для получения новых знаний?
Не упусти главного с нашим telegram-каналом: https://kiozk.ru/s/voyrl